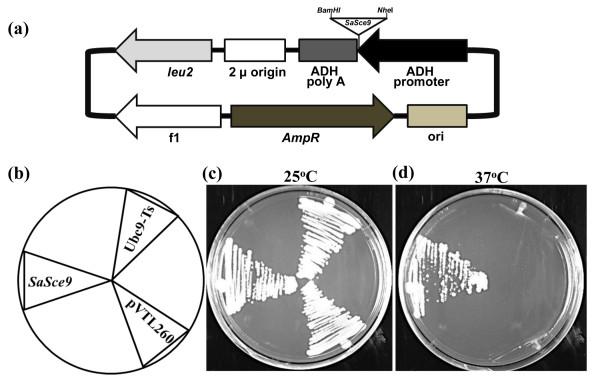
https://cdn.ncbi.nlm.nih.gov/pmc/blobs/5093/3534225/3ed365bfd090/1471-2229-12-187-2.jpg

来自盐生草本植物互花米草的一种应激诱导 SUMO 连接酶基因 (SaSce9) 增强了拟南芥的耐盐和耐旱性。
A stress inducible SUMO conjugating enzyme gene (SaSce9) from a grass halophyte Spartina alterniflora enhances salinity and drought stress tolerance in Arabidopsis.
机构信息
School of Plant, Environmental, and Soil Sciences, Louisiana State University Agricultural Center, Baton Rouge, LA 70803, USA.
出版信息
BMC Plant Biol. 2012 Oct 10;12:187. doi: 10.1186/1471-2229-12-187.
BACKGROUND
SUMO (Small Ubiquitin related Modifier) conjugation is a post translational regulatory process found in all eukaryotes, mediated by SUMO activating enzyme, SUMO conjugating enzyme, and SUMO ligase for the attachment of SUMO to its target protein. Although the mechanism for regulation of SUMO conjugation pathway genes under abiotic stress has been studied to certain extent, the role of SUMO conjugating enzyme in improving abiotic stress tolerance to plant is largely unexplored. Here, we have characterized a SUMO conjugating enzyme gene 'SaSce9' from a halophytic grass Spartina alterniflora and investigated its role in imparting abiotic stress tolerance.
RESULTS
SaSce9 gene encodes for a polypeptide of 162 amino acids with a molecular weight of 18 kD and isoelectric point 8.43. Amino acid sequence comparisons of SaSce9 with its orthologs from other plant species showed high degree (85-93%) of structural conservation among each other. Complementation analysis using yeast SCE mutant, Ubc9, revealed functional conservation of SaSce9 between yeast and S. alterniflora. SaSce9 transcript was inducible by salinity, drought, cold, and exogenously supplied ABA both in leaves and roots of S. alterniflora. Constitutive overexpression of SaSce9 in Arabidopsis through Agrobacterium mediated transformation improved salinity and drought tolerance of Arabidopsis. SaSce9 overexpressing Arabidopsis plants retained more chlorophyll and proline both under salinity and drought stress. SaSce9 transgenic plants accumulated lower levels of reactive oxygen under salinity stress. Expression analysis of stress responsive genes in SaSce9 Arabidopsis plants revealed the increased expression of antioxidant genes, AtSOD and AtCAT, ion antiporter genes, AtNHX1 and AtSOS1, a gene involved in proline biosynthesis, AtP5CS, and a gene involved in ABA dependent signaling pathway, AtRD22.
CONCLUSIONS
These results highlight the prospect of improving abiotic stress tolerance in plants through genetic engineering of the sumoylation pathway. The study provides evidence that the overexpression of SaSce9 in plant can improve salinity and drought stress tolerance by protecting the plant through scavenging of ROS, accumulation of an osmolyte, proline, and expression of stress responsive genes. In addition, this study demonstrates the potential of the halophyte grass S. alterniflora as a reservoir of abiotic stress related genes for crop improvement.
背景
SUMO(小泛素相关修饰物)缀合是一种在所有真核生物中发现的翻译后调节过程,由 SUMO 激活酶、SUMO 缀合酶和 SUMO 连接酶介导,用于将 SUMO 连接到其靶蛋白上。尽管已经在一定程度上研究了非生物胁迫下 SUMO 缀合途径基因的调节机制,但 SUMO 缀合酶在提高植物非生物胁迫耐受性方面的作用在很大程度上尚未得到探索。在这里,我们从盐生草盐地碱蓬中鉴定了一个 SUMO 缀合酶基因'SaSce9',并研究了它在赋予非生物胁迫耐受性方面的作用。
结果
SaSce9 基因编码一个 162 个氨基酸的多肽,分子量约为 18kD,等电点为 8.43。SaSce9 与其他植物物种的同源物的氨基酸序列比较显示彼此之间具有高度的结构保守性(~85-93%)。使用酵母 SCE 突变体 Ubc9 进行的互补分析表明,SaSce9 在酵母和盐地碱蓬之间具有功能保守性。SaSce9 在盐地碱蓬的叶片和根部中,由盐度、干旱、寒冷和外源施加的 ABA 诱导。通过农杆菌介导的转化,在拟南芥中组成型过表达 SaSce9 提高了拟南芥对盐度和干旱的耐受性。SaSce9 过表达的拟南芥植物在盐度和干旱胁迫下保留了更多的叶绿素和脯氨酸。SaSce9 转基因植物在盐度胁迫下积累的活性氧水平较低。SaSce9 拟南芥植物中应激响应基因的表达分析显示,抗氧化基因 AtSOD 和 AtCAT、离子反运蛋白基因 AtNHX1 和 AtSOS1、脯氨酸生物合成基因 AtP5CS 和参与 ABA 依赖信号通路的基因 AtRD22 的表达增加。
结论
这些结果突出了通过遗传工程 SUMO 化途径提高植物非生物胁迫耐受性的前景。该研究提供的证据表明,通过清除 ROS、积累渗透物脯氨酸和表达应激响应基因,植物中 SaSce9 的过表达可以通过保护植物来提高盐度和干旱胁迫耐受性。此外,这项研究表明,盐生草盐地碱蓬作为与非生物胁迫相关基因的资源库,可用于作物改良。